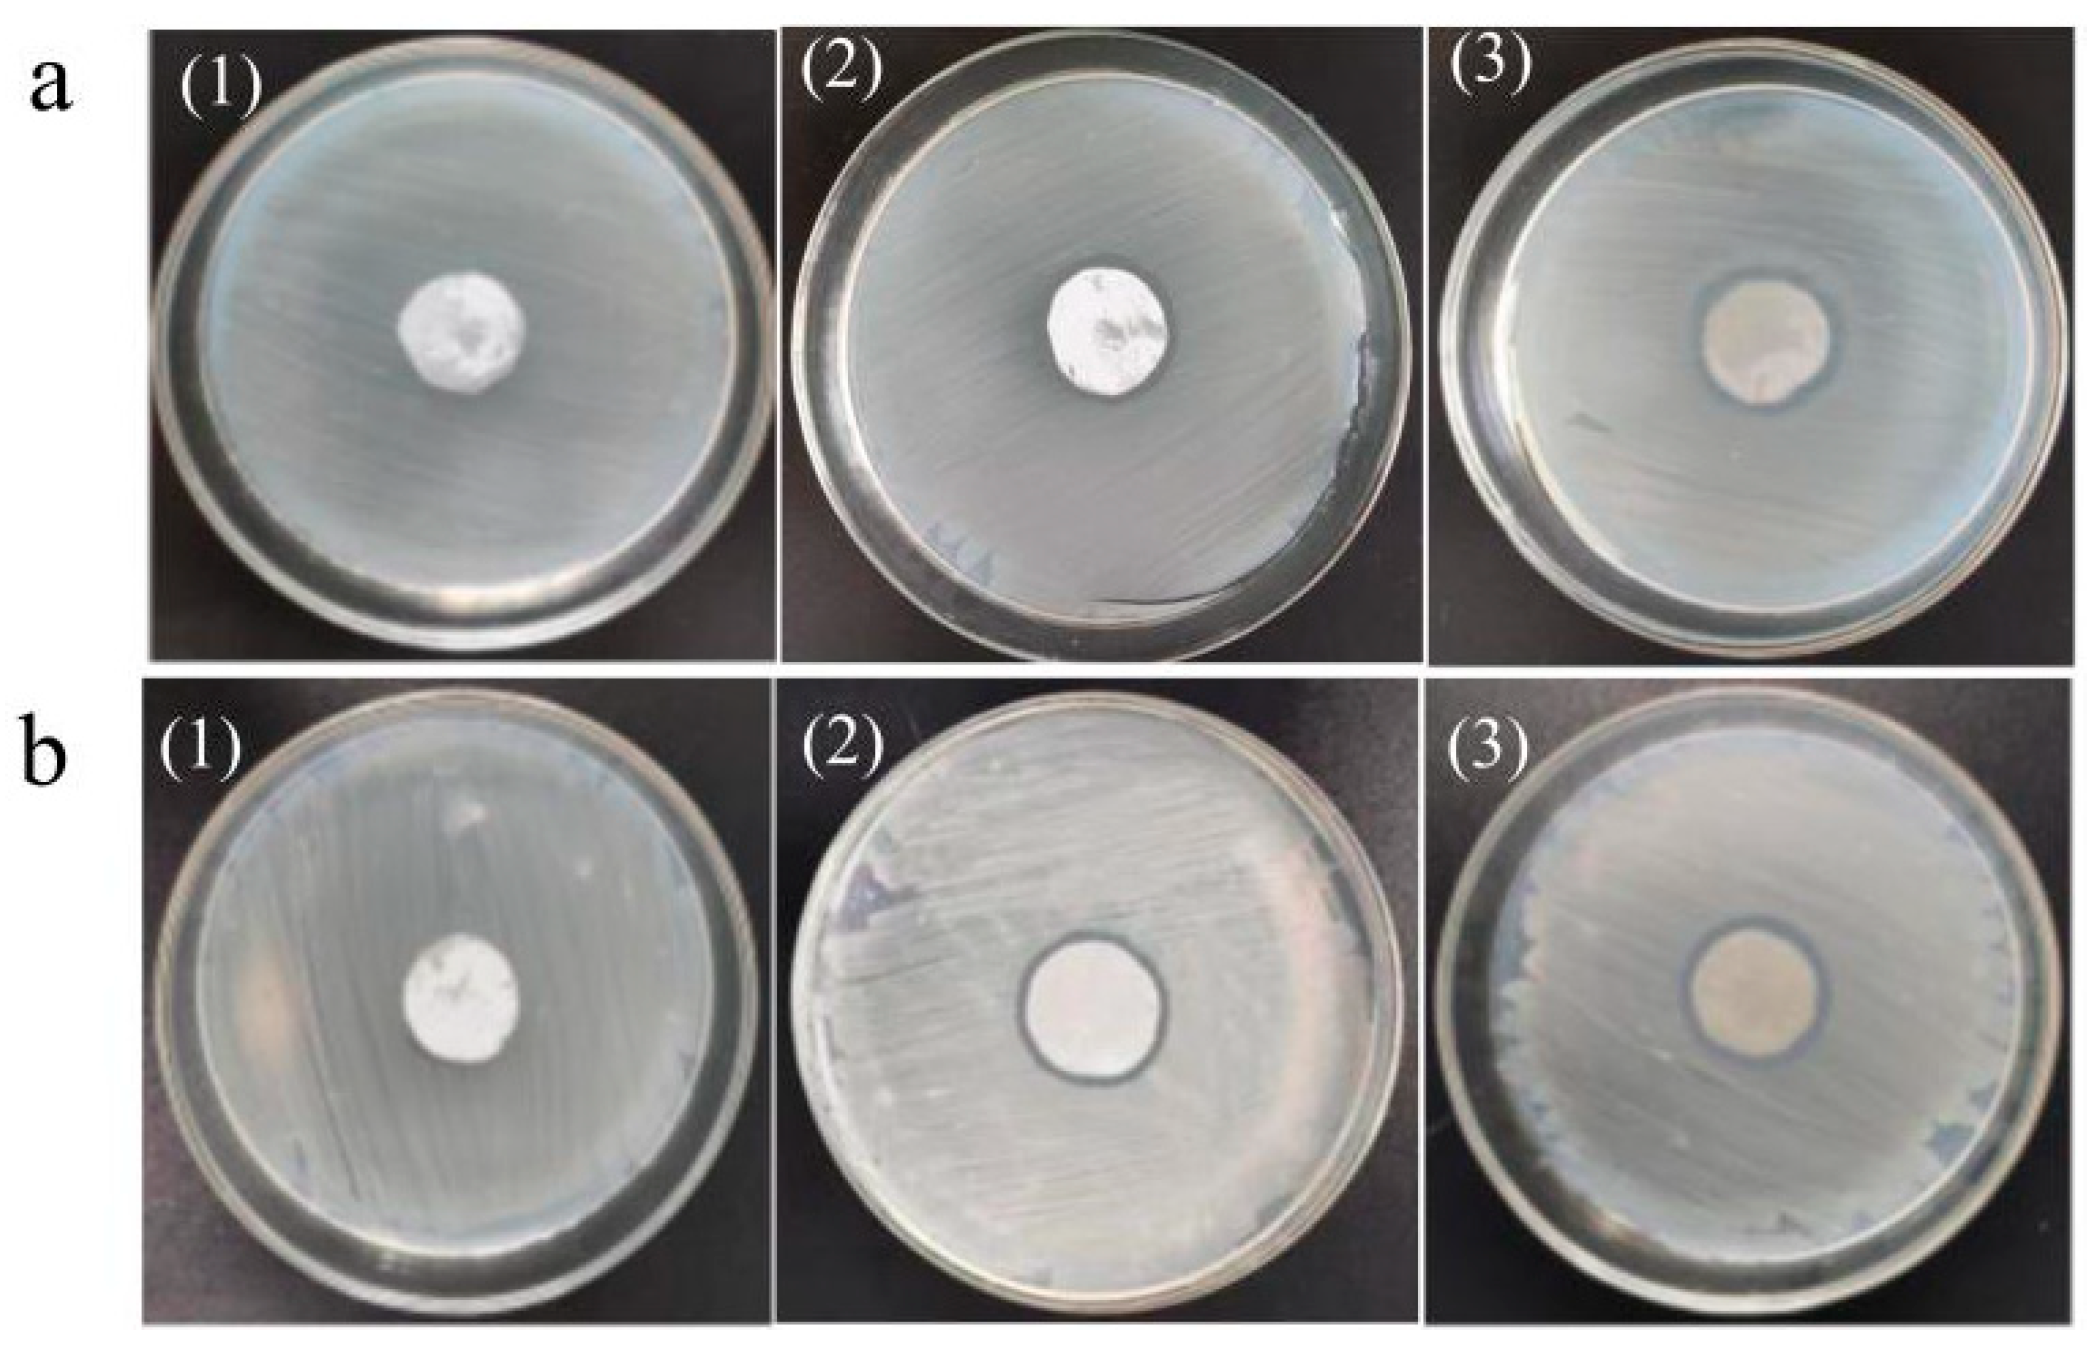

A Novel PVDF Ultrafiltration Membrane Modified by C60(OH)n-Ag
Abstract
1. Introduction
2. Experiment
2.1. Materials
2.2. Preparation and Characterization of the C60(OH)n-Ag Complex
2.3. Preparation of the Ultrafiltration Membrane
2.4. Performance Analysis of the Ultrafiltration Membrane
2.4.1. Physical Performance Analysis
2.4.2. Filtering Performance Test
2.4.3. Retention Accuracy Test
2.4.4. Antibacterial Test
3. Results and Discussion
4. Conclusions
Author Contributions
Funding
Institutional Review Board Statement
Data Availability Statement
Conflicts of Interest
References
- Crini, G.; Lichtfouse, E. Advantages and Disadvantages of Techniques Used for Wastewater Treatment. Environ. Chem. Lett. 2019, 17, 145–155. [Google Scholar] [CrossRef]
- Hube, S.; Eskafi, M.; Hrafnkelsdóttir, K.F.; Bjarnadóttir, B.; Bjarnadóttir, M.Á.; Axelsdóttir, S.; Wu, B. Direct Membrane Filtration for Wastewater Treatment and Resource Recovery: A Review. Sci. Total Environ. 2020, 710, 136375. [Google Scholar] [CrossRef] [PubMed]
- Tang, Y.; Lin, Y.; Ma, W.; Wang, X. A Review on Microporous Polyvinylidene Fluoride Membranes Fabricated via Thermally Induced Phase Separation for MF/UF Application. J. Member. Sci. 2021, 639, 119759. [Google Scholar] [CrossRef]
- Zhu, Y.; Wang, J.; Zhang, F.; Gao, S.; Wang, A.; Fang, W.; Jin, J. Zwitterionic Nanohydrogel Grafted PVDF Membranes with Comprehensive Antifouling Property and Superior Cycle Stability for Oil-in-Water Emulsion Separation. Adv. Funct. Mater. 2018, 28, 1804121. [Google Scholar] [CrossRef]
- Kang, G.; Cao, Y. Application and Modification of Poly(Vinylidene Fluoride) (PVDF) Membranes—A Review. J. Membr. Sci. 2014, 463, 145–165. [Google Scholar] [CrossRef]
- Liu, H.; Liu, X.; Zhao, F.; Liu, Y.; Liu, L.; Wang, L.; Geng, C.; Huang, P. Preparation of a Hydrophilic and Antibacterial Dual Function Ultrafiltration Membrane with Quaternized Graphene Oxide as a Modifier. J. Colloid Interface Sci. 2020, 562, 182–192. [Google Scholar] [CrossRef]
- Yang, Z.; Fan, Y.; Ma, X.; Dong, X.; Chang, M.; Zhu, B.; Liu, R. Antifouling Capability of Polyvinylidene Fluoride Ultrafiltration Membranes Prepared with Poly Sulfobetaine Methacrylate-Modified Graphene Oxide. Colloids Surf. Physicochem. Eng. Asp. 2024, 686, 133270. [Google Scholar] [CrossRef]
- Ayyaru, S.; Ahn, Y.-H. Application of Sulfonic Acid Group Functionalized Graphene Oxide to Improve Hydrophilicity, Permeability, and Antifouling of PVDF Nanocomposite Ultrafiltration Membranes. J. Membr. Sci. 2017, 525, 210–219. [Google Scholar] [CrossRef]
- Tofighy, M.A.; Mohammadi, T.; Sadeghi, M.H. High-flux PVDF/PVP Nanocomposite Ultrafiltration Membrane Incorporated with Graphene Oxide Nanoribbones with Improved Antifouling Properties. J. Appl. Polym. Sci. 2021, 138, 49718. [Google Scholar] [CrossRef]
- Farahani, M.H.D.A.; Vatanpour, V. A Comprehensive Study on the Performance and Antifouling Enhancement of the PVDF Mixed Matrix Membranes by Embedding Different Nanoparticulates Clay, Functionalized Carbon Nanotube, SiO2 and TiO2. Sep. Purif. Technol. 2018, 197, 372–381. [Google Scholar] [CrossRef]
- Liu, C.; Wang, W.; Li, Y.; Cui, F.; Xie, C.; Zhu, L.; Shan, B. PMWCNT/PVDF Ultrafiltration Membranes with Enhanced Antifouling Properties Intensified by Electric Field for Efficient Blood Purification. J. Membr. Sci. 2019, 576, 48–58. [Google Scholar] [CrossRef]
- Xu, Z.; Wu, T.; Shi, J.; Teng, K.; Wang, W.; Ma, M.; Li, J.; Qian, X.; Li, C.; Fan, J. Photocatalytic Antifouling PVDF Ultrafiltration Membranes Based on Synergy of Graphene Oxide and TiO2 for Water Treatment. J. Membr. Sci. 2016, 520, 281–293. [Google Scholar] [CrossRef]
- Tanzi, L.; Terreni, M.; Zhang, Y. Synthesis and Biological Application of Glyco- and Peptide Derivatives of Fullerene C60. Eur. J. Med. Chem. 2022, 230, 114104. [Google Scholar] [CrossRef] [PubMed]
- Goodarzi, S.; Da Ros, T.; Conde, J.; Sefat, F.; Mozafari, M. Fullerene: Biomedical Engineers Get to Revisit an Old Friend. Mater. Today 2017, 20, 460–480. [Google Scholar] [CrossRef]
- Semenov, K.N.; Charykov, N.A.; Postnov, V.N.; Sharoyko, V.V.; Vorotyntsev, I.V.; Galagudza, M.M.; Murin, I.V. Fullerenols: Physicochemical Properties and Applications. Prog. Solid State Chem. 2016, 44, 59–74. [Google Scholar] [CrossRef]
- Wang, T.; Zang, Z.; Wang, S.; Liu, Y.; Wang, H.; Wang, W.; Hu, X.; Sun, J.; Tai, F.; He, R. Quaternary Ammonium Iminofullerenes Promote Root Growth and Osmotic-Stress Tolerance in Maize via ROS Neutralization and Improved Energy Status. Plant Physiol. Biochem. 2021, 164, 122–131. [Google Scholar] [CrossRef]
- Kokubo, K.; Shirakawa, S.; Kobayashi, N.; Aoshima, H.; Oshima, T. Facile and Scalable Synthesis of a Highly Hydroxylated Water-Soluble Fullerenol as a Single Nanoparticle. Nano Res. 2011, 4, 204–215. [Google Scholar] [CrossRef]
- Chakrabarty, B.; Ghoshal, A.K.; Purkait, M.K. Effect of Molecular Weight of PEG on Membrane Morphology and Transport Properties. J. Membr. Sci. 2008, 309, 209–221. [Google Scholar] [CrossRef]
- Zhang, Z.; An, Q.; Liu, T.; Zhou, Y.; Qian, J.; Gao, C. Fabrication of Polysulfone Ultrafiltration Membranes of a Density Gradient Cross Section with Good Anti-Pressure Stability and Relatively High Water Flux. Desalination 2011, 269, 239–248. [Google Scholar] [CrossRef]
- Liu, M.; Chen, Q.; Lu, K.; Huang, W.; Lü, Z.; Zhou, C.; Yu, S.; Gao, C. High Efficient Removal of Dyes from Aqueous Solution through Nanofiltration Using Diethanolamine-Modified Polyamide Thin-Film Composite Membrane. Sep. Purif. Technol. 2017, 173, 135–143. [Google Scholar] [CrossRef]
- Penkova, A.V.; Dmitrenko, M.E.; Sokolova, M.P.; Chen, B.; Plisko, T.V.; Markelov, D.A.; Ermakov, S.S. Impact of Fullerene Loading on the Structure and Transport Properties of Polysulfone Mixed-Matrix Membranes. J. Mater. Sci. 2016, 51, 7652–7659. [Google Scholar] [CrossRef]
- Wu, Y.; Zhao, D.; Ren, J.; Qiu, Y.; Deng, M. A Novel Pebax-C60(OH)24/PAN Thin Film Composite Membrane for Carbon Dioxide Capture. Sep. Purif. Technol. 2019, 215, 480–489. [Google Scholar] [CrossRef]
- Hanaa, D.; Youssef, A.; El-Metwally, E.; Abdelaal, M. Preparation and Characterization of Novel Poly(MMA-Co-GMA)/Ag Nanocomposites for Biomedical Applications. Egypt. J. Chem. 2019, 62, 2245–2252. [Google Scholar] [CrossRef]
- Ko, H.; Singamaneni, S.; Tsukruk, V.V. Nanostructured Surfaces and Assemblies as SERS Media. Small 2008, 4, 1576–1599. [Google Scholar] [CrossRef] [PubMed]
- Ahmad, T.; Guria, C.; Mandal, A. Optimal Synthesis of High Fouling-Resistant PVC-Based Ultrafiltration Membranes with Tunable Surface Pore Size Distribution and Ultralow Water Contact Angle for the Treatment of Oily Wastewater. Sep. Purif. Technol. 2021, 257, 117829. [Google Scholar] [CrossRef]
- Zinadini, S.; Zinatizadeh, A.A.; Rahimi, M.; Vatanpour, V.; Zangeneh, H. Preparation of a Novel Antifouling Mixed Matrix PES Membrane by Embedding Graphene Oxide Nanoplates. J. Membr. Sci. 2014, 453, 292–301. [Google Scholar] [CrossRef]
- Jiang, Z.; Karan, S.; Livingston, A.G. Membrane Fouling: Does Microscale Roughness Matter? Ind. Eng. Chem. Res. 2020, 59, 5424–5431. [Google Scholar] [CrossRef]
- Arefi-Oskoui, S.; Vatanpour, V.; Khataee, A. Development of a Novel High-Flux PVDF-Based Ultrafiltration Membrane by Embedding Mg-Al Nanolayered Double Hydroxide. J. Ind. Eng. Chem. 2016, 41, 23–32. [Google Scholar] [CrossRef]
- Kang, S.; Asatekin, A.; Mayes, A.; Elimelech, M. Protein Antifouling Mechanisms of PAN UF Membranes Incorporating PAN-g-PEO Additive. J. Membr. Sci. 2007, 296, 42–50. [Google Scholar] [CrossRef]
- Wang, J.; Yang, S.; Guo, W.; Ngo, H.-H.; Jia, H.; Yang, J.; Zhang, H.; Zhang, X. Characterization of Fouling Layers for In-Line Coagulation Membrane Fouling by Apparent Zeta Potential. RSC Adv. 2015, 5, 106087–106093. [Google Scholar] [CrossRef]
- Kishore Chand, A.A.; Bajer, B.; Schneider, E.S.; Mantel, T.; Ernst, M.; Filiz, V.; Glass, S. Modification of Polyacrylonitrile Ultrafiltration Membranes to Enhance the Adsorption of Cations and Anions. Membranes 2022, 12, 580. [Google Scholar] [CrossRef] [PubMed]
- Meringolo, C.; Mastropietro, T.F.; Poerio, T.; Fontananova, E.; De Filpo, G.; Curcio, E.; Di Profio, G. Tailoring PVDF Membranes Surface Topography and Hydrophobicity by a Sustainable Two-Steps Phase Separation Process. ACS Sustain. Chem. Eng. 2018, 6, 10069–10077. [Google Scholar] [CrossRef]
- Hudaib, B.; Abu-Zurayk, R.; Waleed, H.; Ibrahim, A.A. Fabrication of a Novel (PVDF/MWCNT/Polypyrrole) Antifouling High Flux Ultrafiltration Membrane for Crude Oil Wastewater Treatment. Membranes 2022, 12, 751. [Google Scholar] [CrossRef] [PubMed]
- Pishbin, R.; Mohammadi, T.; Tofighy, M.A. PVDF Ultrafiltration Membranes Containing Copper Oxide-Charcoal Based Graphene Oxide Nanohybrids with Enhanced Performance and Antifouling Properties. Process Saf. Environ. Prot. 2023, 176, 180–195. [Google Scholar] [CrossRef]
- Zeng, G.; He, Y.; Yu, Z.; Zhan, Y.; Ma, L.; Zhang, L. Preparation and Characterization of a Novel PVDF Ultrafiltration Membrane by Blending with TiO2-HNTs Nanocomposites. Appl. Surf. Sci. 2016, 371, 624–632. [Google Scholar] [CrossRef]
- Li, J.; Sun, J.; Ren, L.; Lei, T.; Li, J.; Jin, J.; Luo, S.; Qin, S.; Gao, C.; Lei, T. Properties and Preparation of TiO2-HAP@PVDF Composite Ultrafiltration Membranes. Polym Compos. 2023, 44, 7499–7509. [Google Scholar] [CrossRef]

| Samples | Cross-Sectional Area/mm2 | Tensile Strength/N·mm−2 | Elongation at Break/% |
|---|---|---|---|
| PVDF ultrafiltration membrane | 1.00 | 6.00 | 21.50 |
| C60(OH)n/PVDF ultrafiltration membrane | 1.00 | 4.82 | 17.05 |
| C60(OH)n-Ag/PVDF ultrafiltration membrane | 1.00 | 5.18 | 19.02 |
| Samples | Ra (nm) |
|---|---|
| PVDF ultrafiltration membrane | 34.5 |
| C60(OH)n/PVDF ultrafiltration membrane | 26.4 |
| C60(OH)n-Ag/PVDF ultrafiltration membrane | 24.4 |
| Samples | Mean Porosity (ε (%)) | Mean Aperture (r (nm)) | Water Flux (L·m−2·h−1) | Rejection Rate (%) |
|---|---|---|---|---|
| PVDF | 68.50 | 54.91 | 224.11 | 75.00 |
| C60(OH)n/PVDF | 79.53 | 40.52 | 835.50 | 92.52 |
| C60(OH)n-Ag/PVDF | 75.88 | 39.22 | 804.05 | 96.44 |
| Membrane | Water Contact Angle (°) | Water Flux (L·m−2·h−1) | BSA Rejection (%) | Ref. |
|---|---|---|---|---|
| PSBMA@GO/PVDF | 64.7° | 50 | 96 | [7] |
| PVDF-SGO | 50° | 740 | 98 | [8] |
| PVDF/GONRs/PVP | 56.5° | 532.28 | 98 | [9] |
| QGO/PVDF | 55.4° | 981~1285 | 84 | [6] |
| MWCNTs-COOH/PVDF | 74° | 250–350 | Close to 100 | [10] |
| PMWCNT/PVDF | 66.6° | 384 | 91 | [11] |
| PVDF/MWCNT/Polypyrrole | 65° | 554.3 | ---- | [33] |
| PVDF/GO-CuO | 60.53° | 178.8 | 94.28 | [34] |
| TiO2-HNTs/PVDF | 59.7° | 354.2 | 75 | [35] |
| TiO2-HAP@PVDF | 74° | 350 | 58.75 | [36] |
| C60(OH)n-Ag/PVDF | 34.5° | 804.05 | 96.44 | This work |
| Samples | PVDF Ultrafiltration Membrane | C60(OH)n/PVDF Ultrafiltration Membrane | C60(OH)n-Ag/PVDF Ultrafiltration Membrane | |
|---|---|---|---|---|
| Rejection Rate | ||||
| BSA % | 75.00 | 92.52 | 96.44 | |
| OVA % | 65.60 | 88.80 | 92.23 | |
| PS % | 64.84 | 86.61 | 90.36 | |
| TPS % | 35.81 | 52.41 | 57.44 | |
| Samples | Antimicrobial Diameter D/mm | |
|---|---|---|
| Escherichia coli | Staphylococcus aureus | |
| PVDF ultrafiltration membrane | 20 ± 0.00 | 20 ± 0.00 |
| C60(OH)n/PVDF ultrafiltration membrane | 21 ± 0.51 | 21 ± 0.43 |
| C60(OH)n-Ag/PVDF ultrafiltration membrane | 23 ± 0.35 | 23 ± 0.45 |
Disclaimer/Publisher’s Note: The statements, opinions and data contained in all publications are solely those of the individual author(s) and contributor(s) and not of MDPI and/or the editor(s). MDPI and/or the editor(s) disclaim responsibility for any injury to people or property resulting from any ideas, methods, instructions or products referred to in the content. |
© 2024 by the authors. Licensee MDPI, Basel, Switzerland. This article is an open access article distributed under the terms and conditions of the Creative Commons Attribution (CC BY) license (https://creativecommons.org/licenses/by/4.0/).
Share and Cite
Zhang, J.; Zhao, W.; Shi, C.; Zhao, L.; Chu, Y.; Ren, Y.; Wang, Q.; Chi, Y.; Zhou, S. A Novel PVDF Ultrafiltration Membrane Modified by C60(OH)n-Ag. Polymers 2024, 16, 3359. https://doi.org/10.3390/polym16233359
Zhang J, Zhao W, Shi C, Zhao L, Chu Y, Ren Y, Wang Q, Chi Y, Zhou S. A Novel PVDF Ultrafiltration Membrane Modified by C60(OH)n-Ag. Polymers. 2024; 16(23):3359. https://doi.org/10.3390/polym16233359
Chicago/Turabian StyleZhang, Jie, Wenjun Zhao, Chengyang Shi, Liman Zhao, Yudi Chu, Yanan Ren, Qun Wang, Yanxia Chi, and Shujing Zhou. 2024. "A Novel PVDF Ultrafiltration Membrane Modified by C60(OH)n-Ag" Polymers 16, no. 23: 3359. https://doi.org/10.3390/polym16233359
APA StyleZhang, J., Zhao, W., Shi, C., Zhao, L., Chu, Y., Ren, Y., Wang, Q., Chi, Y., & Zhou, S. (2024). A Novel PVDF Ultrafiltration Membrane Modified by C60(OH)n-Ag. Polymers, 16(23), 3359. https://doi.org/10.3390/polym16233359

